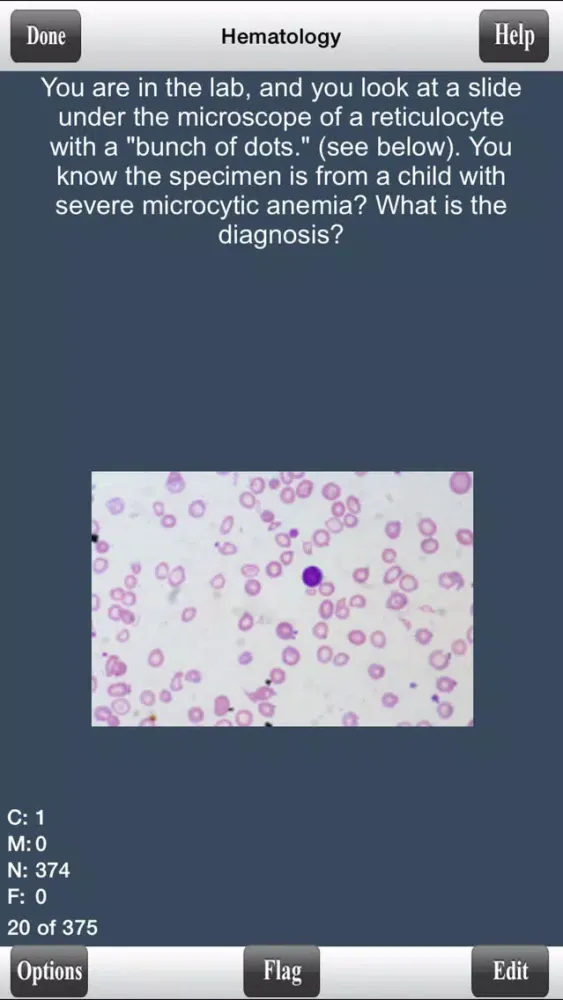

USMLE Step 1 Pathology Flashcards
रेटिंग
Jan 26, 2018नवीनतम अपडेट
2.46संस्करण
USMLE Step 1 Pathology Flashcards के बारे में
Study for the USMLE (United States Medical Licensing Exam) Step 1 with over 3000 questions that will help you master the material to do well on Step 1 of the USMLE. Pathology is the most heavily tested subject on Step 1.
Here are the topics and flashcards included in this program:
Inflammation: 126 flashcards
Acid/Base Blood Gas:38 flashcards
Nutrition and Disease: 140 flashcards
Clotting: 134 flashcards
Cellular Changes: 48 flashcards
Cell Cycle: 62 flashcards
Cellular Injury: 118 flashcards
Fluid Shifts: 161 flashcards
Hematology: 375 flashcards
GI: 365 flashcards
Kidney: 164 flashcards
Urology: 51 flashcards
Gynecology: 125 flashcards
MSK: 98 flashcards
Skin: 31 flashcards
Neuro: 75 flashcards
Cardiology: 322 flashcards
Respiratory: 226 flashcards
Cancer: 196 flashcards
Endocrine: 205 flashcards
Total # of Questions:3060
The cards were created by students and now physicians who scored a 240 or higher on their USMLE Step 1.
The program itself offers various features and options for a great and convenient learning environment which include:
- Ability to Randomize cards
- Can Flag cards for later use
- Grade cards by using gestures
- Study only missed cards, only new cards, only correct cards, flagged cards, or study all cards
- Study all categories or selected categories
- Timed mode to automatically flip card and advance cards.
- Ability to edit and delete cards
- Convenient statistics panel to see progress
- Can change background color and text color
- Can change text size
- Can see back of card first
You can try out our Lite version to see the features and how to use the program.
Here are the topics and flashcards included in this program:
Inflammation: 126 flashcards
Acid/Base Blood Gas:38 flashcards
Nutrition and Disease: 140 flashcards
Clotting: 134 flashcards
Cellular Changes: 48 flashcards
Cell Cycle: 62 flashcards
Cellular Injury: 118 flashcards
Fluid Shifts: 161 flashcards
Hematology: 375 flashcards
GI: 365 flashcards
Kidney: 164 flashcards
Urology: 51 flashcards
Gynecology: 125 flashcards
MSK: 98 flashcards
Skin: 31 flashcards
Neuro: 75 flashcards
Cardiology: 322 flashcards
Respiratory: 226 flashcards
Cancer: 196 flashcards
Endocrine: 205 flashcards
Total # of Questions:3060
The cards were created by students and now physicians who scored a 240 or higher on their USMLE Step 1.
The program itself offers various features and options for a great and convenient learning environment which include:
- Ability to Randomize cards
- Can Flag cards for later use
- Grade cards by using gestures
- Study only missed cards, only new cards, only correct cards, flagged cards, or study all cards
- Study all categories or selected categories
- Timed mode to automatically flip card and advance cards.
- Ability to edit and delete cards
- Convenient statistics panel to see progress
- Can change background color and text color
- Can change text size
- Can see back of card first
You can try out our Lite version to see the features and how to use the program.
USMLE Step 1 Pathology Flashcards स्क्रीनशॉट
USMLE Step 1 Pathology Flashcards iPad स्क्रीनशॉट
संपादक की सिफारिश
USMLE Step 1 Pathology Flashcards जैसे ऐप्स
Virtual Flashcards द्वारा ऐप्स
USMLE Step 1 Pathology Flashcards FAQ
मैं PGYER IPA HUB से USMLE Step 1 Pathology Flashcards कैसे डाउनलोड करूं?
PGYER IPA HUB पर USMLE Step 1 Pathology Flashcards मुफ्त डाउनलोड करने के लिए है?
PGYER IPA HUB से USMLE Step 1 Pathology Flashcards डाउनलोड करने के लिए मुझे एक खाता चाहिए?
मैं PGYER IPA HUB पर USMLE Step 1 Pathology Flashcards के साथ समस्या कैसे रिपोर्ट कर सकता हूँ?
क्या आपको यह मददगार पाया
हाँ
नहीं
सबसे लोकप्रिय
Sing It - Ear TrainerA must app for every musician, singer, or just for fun.
Test,train, and improve your musical ear and
Tube PiP - PiP for YouTubeTube PiP - the ultimate YouTube companion for iOS:
Picture in Picture (PiP) Playback: Watch YouTube
Papaya Ouch!In the game Papaya Ouch!, you can experience backpack management, tower defense, TD, merge, match 2,
Lets Go VPNLets Go VPN, the most advanced VPN, is designed by a team of top developers who strive to ensure all
Paprika Recipe Manager 3Organize your recipes. Create grocery lists. Plan your meals. Download recipes from your favorite we
War Pigeons UnboundedWar is coming. Deep down in top secret military labs they have evolved, mutated - and escaped. The f
Procreate PocketApp of the Year winner Procreate Pocket is the most feature-packed and versatile art app ever design
Cowboy Westland survival runAre you ready to take part in the #1 exciting 3D western adventure? Cowboy Westland survival run mak
Max: Stream HBO, TV, & MoviesIt’s all here. Iconic series, award-winning movies, fresh originals, and family favorites, featuring
TonalEnergy Tuner & MetronomeFor musicians from pros to beginners, whether you sing, play a brass, woodwind or stringed instrumen
SkyView®SkyView® brings stargazing to everyone. Simply point your iPhone, iPad, or iPod at the sky to identi
Ninja Dash 2015Ninja Dash 2015 is the fast paced running game!On these maze fields, rush to the end of this ninja w
Tami-Live Chat&VideoTami is an app that records daily life and ideas.You can use it to record your every day, whether it
SALE Camera - marketing camera effects plus photo editorSALE Camera Help you create the best Business to consumer Stock Photos and Images. provides 300 filt
DevTutor for SwiftUI"DevTutor" is an application designed to assist developers in creating exceptional apps us
Mokens League SoccerDive into Mokens League Soccer and experience the new era of soccer gaming!
Esports for Everyone: Wh
Zombie ZZOMBIE ENDLESS RUNNER LIKES NO OTHER!WHY?* Awesome graphic quality!* Simplified control (Auto-shooti
Dead Z - Zombie SurvivalCatastrophic explosion at the Omega Labs started the apocalypse, now spreading across the Earth.
Tak
HotSchedulesHotSchedules is the industry's leading employee scheduling app because it’s the fastest and easiest
ChatGPTIntroducing ChatGPT for iOS: OpenAI’s latest advancements at your fingertips.
This official app is f
Disney StoreDisney Store is your official home for exclusive collections, designer collaborations, and one-of-a-
fight back tennisa Pong game with Tennis style, the gameplay itself is very simple, you can using Touch. Ball speed w
Dr. Mina AdlyMina Adly mobile app provides students with portable instant access to a selection of services.
Usin
iVerify BasiciVerify Basic is your gateway to enhanced device security and threat awareness, offering a glimpse i